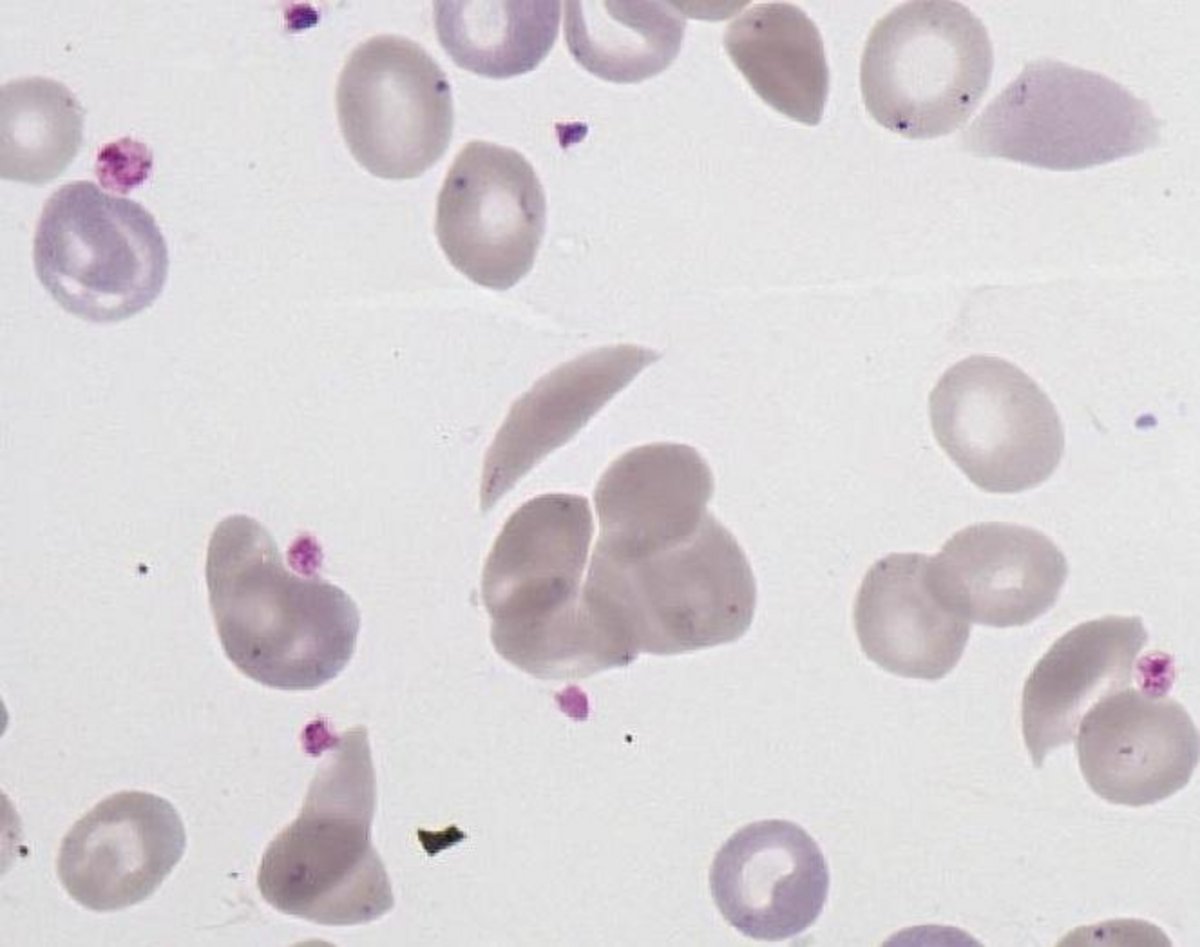
Sickle_cell

Sickle cell
- Size : N/A
- Normal values : Absent in the blood
- Description / Pathology :
Sickle cells.
A genetic mutation causes the polymerization in long fibers of the Hemoglobin S in the RBC, that becomes sickle-shaped with pointed ends.
Sickle cell anemia.